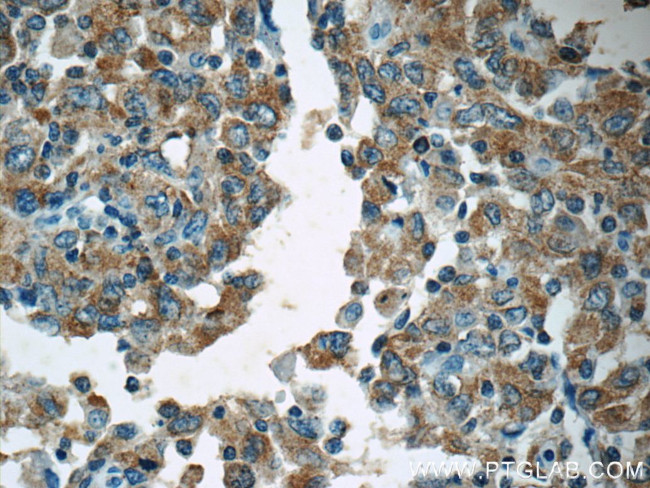
APC Antibody in Immunohistochemistry (Paraffin) (IHC (P))

Search
Proteintech
APC Polyclonal Antibody
{{$productOrderCtrl.translations['antibody.pdp.commerceCard.promotion.promotions']}}
{{$productOrderCtrl.translations['antibody.pdp.commerceCard.promotion.viewpromo']}}
{{$productOrderCtrl.translations['antibody.pdp.commerceCard.promotion.promocode']}}: {{promo.promoCode}} {{promo.promoTitle}} {{promo.promoDescription}}. {{$productOrderCtrl.translations['antibody.pdp.commerceCard.promotion.learnmore']}}
产品信息
19782-1-AP
种属反应
宿主/亚型
分类
类型
抗原
偶联物
形式
浓度
规格
纯化类型
保存液
内含物
保存条件
运输条件
靶标信息
This gene encodes a tumor suppressor protein that acts as an antagonist of the Wnt signaling pathway. It is also involved in other processes including cell migration and adhesion, transcriptional activation, and apoptosis. Defects in this gene cause familial adenomatous polyposis (FAP), an autosomal dominant pre-malignant disease that usually progresses to malignancy. Disease-associated mutations tend to be clustered in a small region designated the mutation cluster region (MCR) and result in a truncated protein product.
仅用于科研。不用于诊断过程。未经明确授权不得转售。
生物信息学
蛋白别名: adenomatosis polyposis coli tumor suppressor; adenomatous polyposis coli; adenomatous polyposis coli (APC); Adenomatous polyposis coli protein; APC; APC, WNT signaling pathway regulator; Deleted in polyposis 2.5; epididymis secretory sperm binding protein; FAP; FPC; Protein APC; protein phosphatase 1, regulatory subunit 46; Unknown; unnamed protein product; WNT signaling pathway regulator
基因别名: APC; BTPS2; DESMD; DP2; DP2.5; DP3; GS; PPP1R46
UniProt ID: (Human) P25054
Entrez Gene ID: (Human) 324